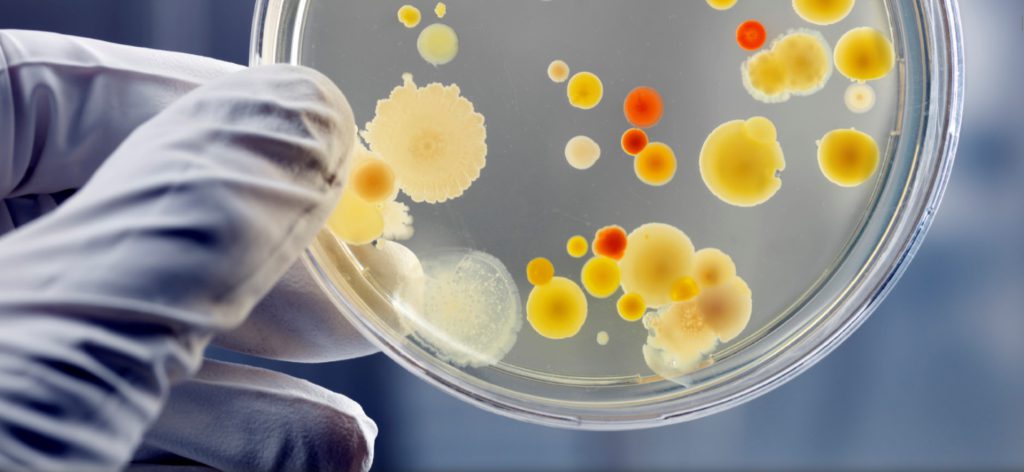

Featured insights
Featured insights
Hospital Grade Disinfection
Minntech, a leading manufacturer in disinfection technology, offers two powerful sporicides through Mar Cor Purification. Minncare® Cold Sterilant is a concentrated disinfectant and sterilant. Actril® Cold Sterilant is a Ready-To-Use disinfectant and sterilant with no dilution required. Both are proven effective for use against spores, bacteria, viruses and molds on…
Read more


